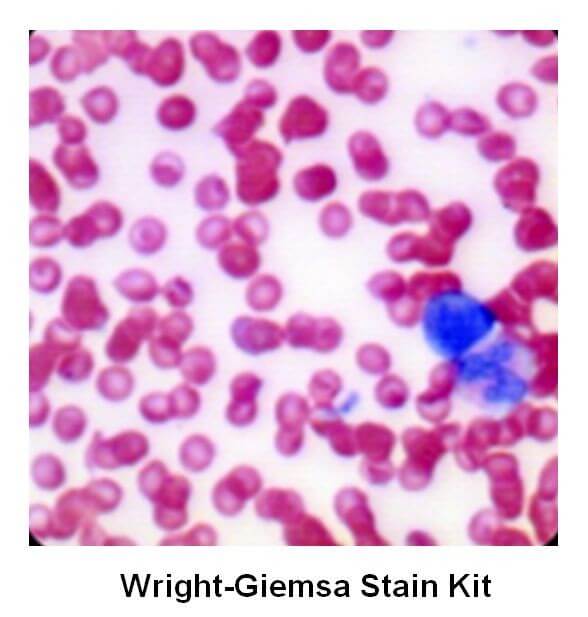

Twort’s Counter stain Kit |細胞質細胞核染劑 貨號K1436-125
| 代理廠牌: |  |
| 原廠連結: | |
| 相關下載: |
特點
Twort’s Counterstain Kit | 貨號K1436-125
產品描述:Twort的Counterstain Kit專為組織學程序設計,以提供對比度,使組織切片更易於觀察。 細胞核:紅色,細胞質:淺綠色

| Cat # +Size | K1436-125 |
| Size | 125 ml |
| Applications | • Histological applications • For in vitro diagnostic use |
| Features & Benefits | To provide contrast for easier visualization of tissue sections. |
| Kit Components | • Twort’s Neutral Red (Part A) • Twort’s Fast Green (Part B) • Acetic Alcohol Solution (2%) |